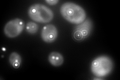
YPR035W
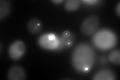
YPR035W

View description
Glutamine synthetase (GS), synthesizes glutamine from glutamate and ammonia; with Glt1p, forms the secondary pathway for glutamate biosynthesis from ammonia; expression regulated by nitrogen source and by amino acid limitation
Localization:
Intensity:
Fold change:
Significance:
-
C’ GFP library in SD

cytosol1579.7 -
N' NOP1pr-GFP in SD

N/A0 -
N' TEF2pr-mCherry in SD

N/A0 -
N' NATIVEpr-GFP in SD

N/A0 -
N' TEF2pr-VC and Cyto-VN in SD

N/A0 -
C’ GFP library in SD+DTT

cytosol963.730.61Yes -
C’ GFP library in SD+H2O2

cytosol1698.571.07No -
C’ GFP library in Starvation Media
punctate, cytosolN/AN/AYes -
C’ GFP library on the background of Pup2-DaMP
punctate -
C’ GFP library on the background of CCT mutant

cytosol1569.630.993625No
